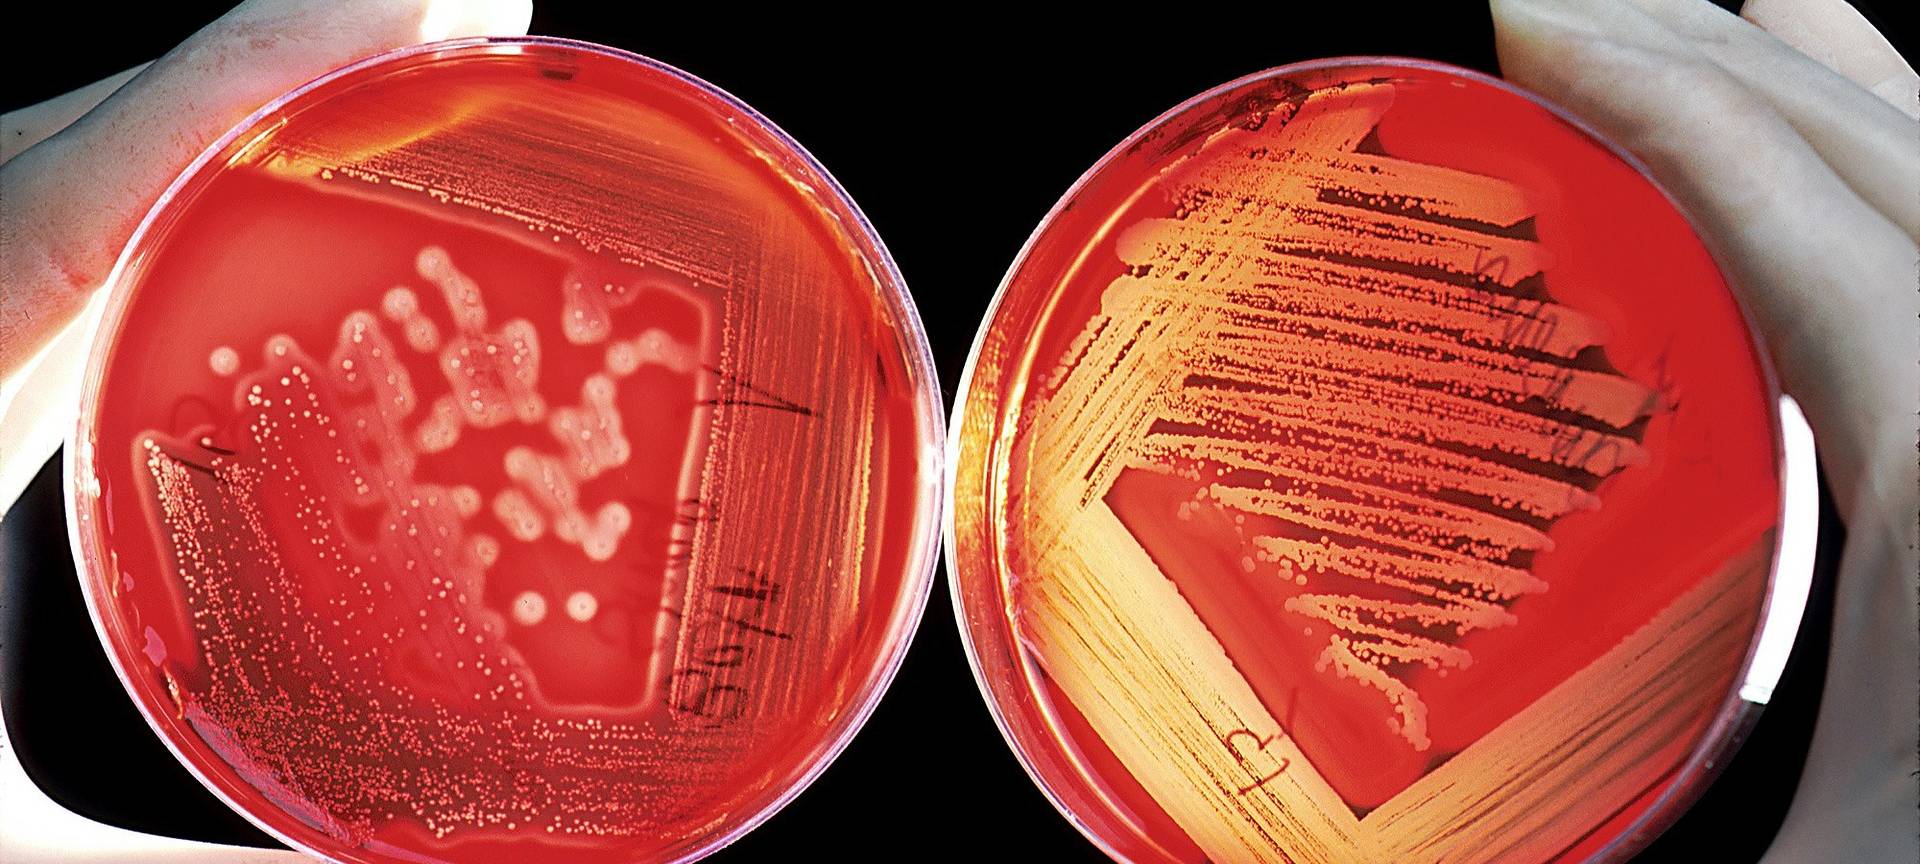
Uniklinik Essen: Reaktionen auf Keime im Trinkwasser
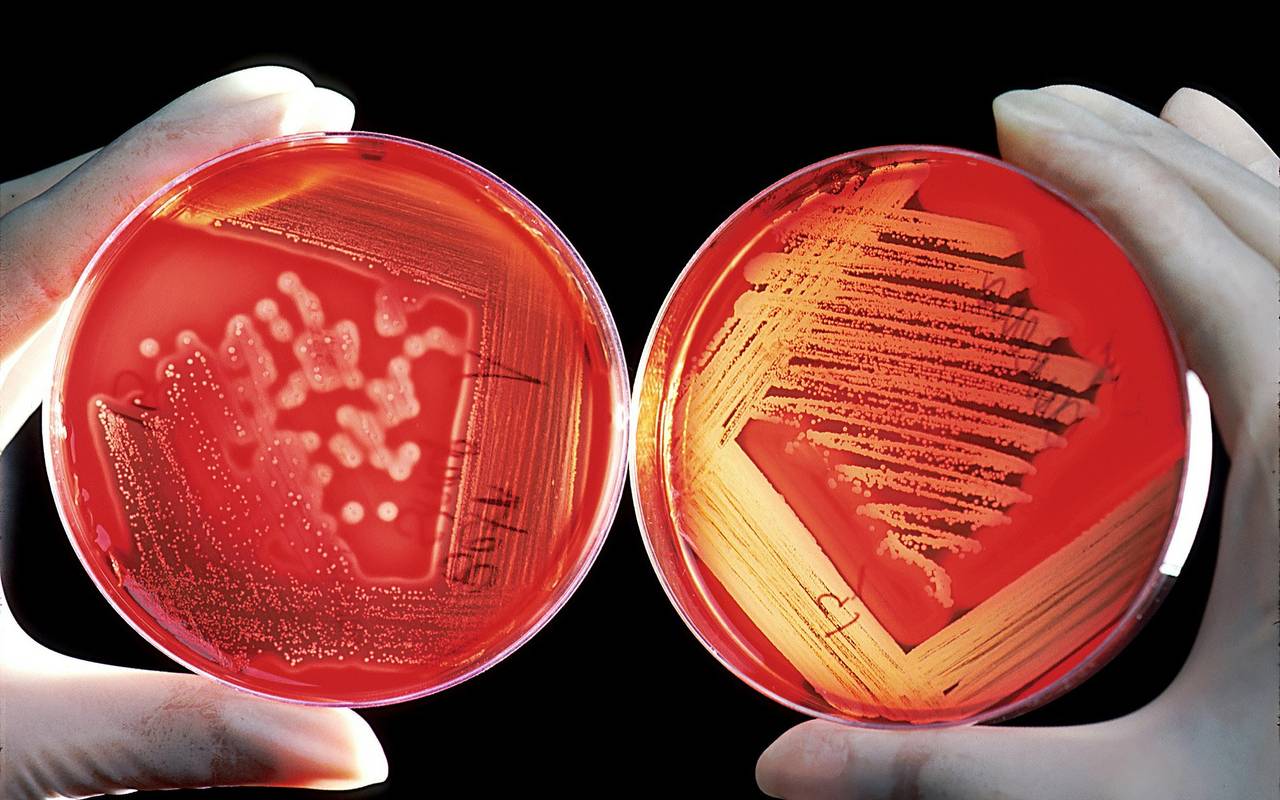

Uniklinik Essen: Reaktionen auf Keime im Trinkwasser
Keime im Trinkwasser: Diese Nachricht der Uniklinik in Essen-Holsterhausen sorgt für Gesprächsstoff in der Stadt. Zwar bezeichnet die Stadt sie als wenig "krankheitserregend", dennoch sind vor allem auf Facebook viele Essener besorgt. Wir sammeln die Reaktionen der Essener, der Stadtwerke und der Uniklinik.
Veröffentlicht: Donnerstag, 12.09.2019 10:08
Trinkwasser-Keime sorgen für Diskussionen
Bei Trinkwasser-Proben an der Uniklinik in Holsterhausen wurden nach Auskunft der Stadt und der Uniklinik sogenannte "coliforme Keime" gefunden. Sie sollen "wenig krankmachende" Erreger sein, sagt die Stadt. Aktuell laufen Untersuchungen von Experten des Gesundheitsamtes und des Instituts für medizinische Mikrobiologie. Detaillierte Informationen gibt es hier. Die Stadt und die Uniklinik rufen Patienten und Klinik-Mitarbeiter dazu auf, kein Wasser aus dem Wasserhahn zu trinken oder es zum Zähneputzen zu verwenden. In Essen hat die Nachricht zu den Keimen für Diskussionen gesorgt.
Stadtwerke Essen wollen Sorgen ernst nehmen
Die Stadtwerke wollen die Sorgen und Bedürfnisse der Essener ernst nehmen, auch wenn sie bislang keine Gefahren befürchten. Radio Essen-Moderator Timm Schröder hat mit Dirk Pomplum, dem Sprecher der Stadtwerke, gesprochen.
Essener diskutieren auf der Radio Essen-Facebookseite
Als das Problem bekannt wird, postet Radio Essen direkt eine entsprechende Nachricht auf Facebook. Darunter wird rege diskutiert. Unter anderem stößt die Formulierung der Stadt vielen Usern negativ auf. Der Begriff "wenig krankmachend" sei im Zusammenhang mit stark immungeschwächten Patienten nicht angebracht, meint Tanja. Auch Stefan ist mit der Formulierung nicht zufrieden: "Entweder man wird davon krank oder nicht", sagt er. Dagmar meint, dass ihr Vertrauen in Krankenhäuser durch die Meldung sinkt. Viele User machen sich zudem Sorgen, dass auch ihr heimisches Trinkwasser mit Keimen belastet ist. Um diese Frage zu klären, nehmen die Stadtwerke aktuell auch Proben in den Wohnvierteln drumherum. Die letzten, routinemäßigen Proben waren alle in Ordnung, heißt es.
Hygieneleitung der Uniklinik zu den Keimen im Trinkwasser
Laut Birgit Ross, Leiterin des Hygiene-Bereichs der Uniklinik handelt es sich im Trinkwasser um Umweltkeime. Diese sind in der Regel nur selten krankheitserregend. Radio Essen Redakteur Christian Bannier spricht mit ihr über bereits durchgeführte Schutzmaßnahmen der Uniklinik. Zum Beispiel gibt es auf der Intensivstation spezielle Filter, die alle Keime aus dem Wasser filtern. Außerdem laufen aktuell noch Untersuchungen, woher die Bakterien kommen. Außerdem erklärt sie, wie das Klinikum jetzt gegen die Keime vorgeht.